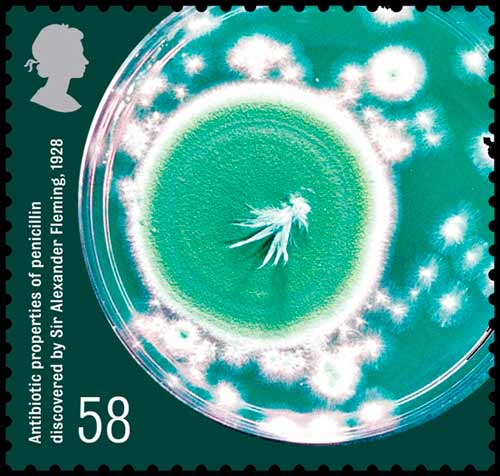

A new series of stamps issued by the British Royal Mail celebrates some of the most important medical discoveries in the country since the late 19th century

First class: The birth of beta-blockers
Originally discovered in the form of propranolol by James W. Black, the drugs that have come to be known as beta blockers have revolutionised the management of heart disease.
They are now widely used for the management of cardiac arrhythmias, protection after myocardial infarction (heart attack), and hypertension, and are one of the most important contributions to clinical medicine and pharmacology of the 20th century.
58p: The serendipitous discovery of penicillin
The discovery of penicillin is a classic case of scientific serendipity. In 1928 Alexander Fleming accidentally left a Petri dish open in his lab, and found that a contamination on the dish of the mould Penicillium notatum inhibited bacterial growth.
Fleming named the substance penicillin, and launched the modern era of antibiotic treatment and discovery.

60p: The total hip replacement
John Charnley began his research into hip replacement when he moved his clinical practice to Wrightington Hospital near Wigan in 1949.
Developing such a complicated procedure was fraught with setbacks, but he finally performed his first successful hip replacement in 1962.

67p: Artificial eye lenses
While Harold Ridley was treating Royal Air Force casualties who were wounded during the second world war, he made a grisly observation. He noticed that when splinters of Perspex from shattered cockpits became lodged in the eyes of pilots, the immune system didn’t reject them.
This led him to the idea of producing artificial lenses that could be implanted in the eye, to correct problems such as cataracts. On 29 November 1949, at St Thomas’ Hospital, London, Ridley achieved the first implant of an intraocular lens – and gave birth to a new and highly successful medical procedure.

88p: Proof that mosquitoes transmit malaria
In 1897, Ronald Ross discovered the presence of the malarial parasite in the Anopheles mosquito. Following the hypothesis of Patrick Manson that malaria was spread by the mosquito, Ross was also able to find the parasite in a mosquito that had sucked the blood of a person who had malaria.
Later on, using birds that were sick with malaria, he was able to ascertain the entire life cycle of the malarial parasite. Most importantly, he demonstrated that malaria is transmitted from infected birds to healthy ones by the bite of a mosquito, a finding that suggested the disease’s mode of transmission to humans.

97p: Computer tomography
Three-dimensional medical scanning may seem like a very recent idea – but its pioneer, Godfrey Hounsfield, thought it was a possibility at the start of the 1970s. He reasoned that you could accurately determine what was inside a box by taking X-ray readings at all angles around the object.
It didn’t take him long to create a prototype, and then test it on a cow’s brain – and his own. His device got its first clinical airing in 1971, successfully imaging a cerebral cyst. Now, the CT scan is an integral part of medical imaging around the globe


